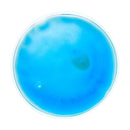
Compresa cald "Relief"
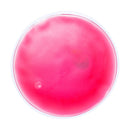
Compresa cald "Relief"

Descriere
Shatter distribuie aceste produse numai la Persoane Juridice.
Pretul este pe bucata, NU include TVA si costuri de personalizare. Pentru detalii despre posibilitati de personalizare si stocuri va rugam sa ne contactati.
TERMEN DE LIVRARE: 2-5 zile LUCRATOARE.